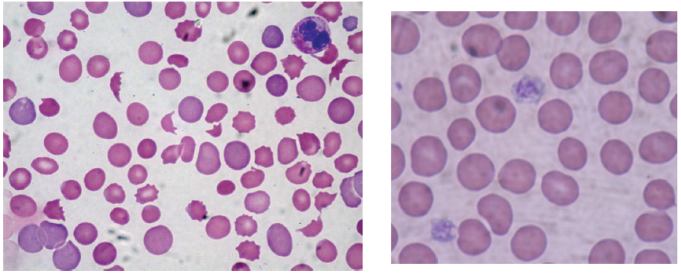

Artigo
MODELIZAR LA EXPRESIÓN DE LOS GENES PARA EL APRENDIZAJE DE ENFERMEDADES GENÉTICAS EN SECUNDARIA
MODELAR EXPRESSÃO GENÉTICA PARA O APRENDIZADO DE DOENÇAS GENÉTICAS NO ENSINO MÉDIO
MODELLING GENE EXPRESSION TO TEACH GENE EXPRESSION IN SECONDARY EDUCATION
MODELIZAR LA EXPRESIÓN DE LOS GENES PARA EL APRENDIZAJE DE ENFERMEDADES GENÉTICAS EN SECUNDARIA
Ensaio Pesquisa em Educação em Ciências (Belo Horizonte), vol. 18, núm. 1, pp. 65-84, 2016
Faculdade de Educação da Universidade Federal de Minas Gerais
Recepción: 01 Junio 2015
Aprobación: 15 Febrero 2016
Financiamiento
Fuente: Ministerio de Economía y Competitividad de España
Nº de contrato: EDU2012-38022-C02-01
RESUMEN: Se presenta el diseño y análisis de una actividad de modelización sobre la expresión de los genes enmarcada en una secuencia didáctica para trabajar enfermedades genéticas con alumnado de secundaria. El estudio se desarrolla en el marco de una tesis doctoral sobre el desempeño de prácticas científicas en el aprendizaje de genética. Proponemos la modelización como medio que ayuda a visibilizar y a comprender los mecanismos implicados en la expresión de los genes. Las preguntas que guían este trabajo son: 1) ¿Cómo son los modelos materiales que elaboran los estudiantes de secundaria para explicar la expresión de los genes?; 2) ¿En qué medida explican la expresión de los genes en base a los modelos elaborados y los relacionan con la anemia falciforme? Los resultados muestran que todos los grupos movilizaron ideas y nociones de genética para elaborar sus modelos materiales, aunque en algunos casos se limitaron a nombrar y a situar los elementos involucrados en la expresión de los genes. Por otro lado, la modelización de la expresión de los genes con el kit permitió al alumnado elaborar una explicación sobre los mecanismos que intervienen en la expresión de los genes. Los cinco grupos lograron ampliar y mejorar sus modelos a la hora de justificarlos por escrito o comunicarlos verbalmente, lo que pone de manifiesto el potencial de un enfoque de modelización basado en las distintas fases propuestas por Justi (2006).
Palabras clave: modelización, modelo de expresión de los genes, prácticas científicas, enfermedades genéticas, anemia falciforme..
RESUMO: Este artigo apresenta o desenho e análise de uma atividade de modelagem sobre a expressão dos genes enquadrada em uma sequência didática para trabalhar doenças genéticas com alunos de Ensino Médio. O estudo se desenvolve a partir de uma tese de doutorado sobre o desempenho de práticas científicas na aprendizagem sobre genética. Propomos a modelagem como meio de que ajuda a dar visibilidade e a entender os mecanismos implicados na expressão genética. As seguintes perguntas guiam este trabalho: 1) Como são os modelos materiais elaborados pelos estudantes de Ensino Médio para explicar a expressão genética?; 2) Em que medida eles explicam a expressão genética com base nos modelos elaborados e os relacionam com a anemia falciforme? Os resultados mostram que todos os grupos mobilizaram ideias e noções de genética para elaborar seus modelos materiais, ainda que em alguns casos eles se limitaram a nomear e a situar os elementos envolvidos na expressão genética. Por outro lado, a modelagem da expressão genética com o kit permitiu aos estudantes elaborar uma explicação sobre os mecanismos que intervém na expressão genética. Os cinco grupos conseguiram ampliar e melhorar seus modelos no momento de justificá-los por escrito ou comunicá-los verbalmente, o que manifesta o potencial de um enfoque de modelagem baseado nas diferentes fases propostas por Justi (2006).
Palavras-chave: Modelagem, Modelo de expressão genética, práticas científicas, doenças genéticas, anemia falciforme.
ABSTRACT: This study presents the design and analysis of a modelling-based activity about gene expression framed in a sequence about genetic diseases for secondary students. The research is part of a broader investigation embedded in a thesis on students' enactment of scientific practices in a Genetics learning context. We propose modelling as a way to visualize and to better understand the mechanisms involved in gene expression. The research questions are: 1) How are the material models that secondary students elaborate in order to explain gene expression?; 2) to what extent do t hey explain gene expression using their material models and are able to relate them with sickle cell disease? The results show that all groups mobilize genetic ideas and notions to build their models, although in some cases they limit to name and locate the elements involved in gene expression. On the other hand, modelling gene expression using the kit allows the students to construct an explanation about the mechanisms participating in gene expression. The five groups expanded and improved their models when they had to justify them in their writing reports or orally. This reveals the potential of using a modelling approach based on the stages proposed by Justi (2006).
Keywords: the gene expression model, scientific practices, modelling, genetic diseases..
INTRODUCCIÓN
Se presenta el diseño y análisis de una actividad de modelización sobre la expresión de los genes integrada en una secuencia didáctica para trabajar enfermedades genéticas de distinta complejidad en secundaria. La secuencia se desarrolla en el marco de una tesis doctoral situada dentro de un proyecto estatal de investigación sobre el uso y la trasferencia de prácticas científicas en el aprendizaje de ciencias. Con este estudio, pretendemos hacer una contribución a la investigación en modelización y a la enseñanza de genética basada en prácticas científicas. Tomando en consideración las dificultades del alumnado para entender y aplicar el modelo de expresión de los genes señaladas por la investigación (Venville y Dawson, 2010), y ante la falta de estudios que aborden el proceso de modelización de expresión de los genes como vía para ayudar a superar estas dificultades, desarrollamos la secuencia didáctica de este artículo. La secuencia pretende promover el desempeño de las prácticas de modelización y argumentación, ambas estrechamente relacionadas (Mendoça y Justi 2014), en articulación con el aprendizaje de nociones científicas necesarias para la explicación de enfermedades genéticas.
Las enfermedades constituyen problemas sociales de gran impacto mediático. La prensa, internet, televisión, entre otros medios, difunden informaciones sobre estas enfermedades que no siempre están bajo una perspectiva adecuada que contemple la influencia de factores ambientales en el desarrollo de estas dolencias. Titulares como "descubren el gen mutado que provoca la muerte súbita", "el gen de la diabetes", sitúan al público ante un paradigma científico en el que el valor de los genes es determinante. Es necesario, por lo tanto, dotar al alumnado de herramientas para superar esta visión. Modelizar la expresión de los genes requiere conectar los distintos mecanismos y moléculas implicadas en la expresión génica, lo que podría ayudar a comprender enfermedades genéticas.
Las preguntas de investigación que guían este trabajo son:
El artículo comienza, en primer lugar, con una presentación del marco teórico relativo a las prácticas científicas y al aprendizaje de genética en secundaria; en segundo lugar, se presenta el diseño de la secuencia, poniendo el foco de atención en discutir el enfoque de la tarea que analizamos; y en tercer lugar, se discuten algunos resultados de su puesta en práctica, terminando con algunas conclusiones e implicaciones derivadas de los resultados obtenidos.
APRENDIZAJE DE LAS CIENCIAS MEDIANTE LA PARTICIPACIÓN EN LAS PRÁCTICAS CIENTÍFICAS
La visión del aprendizaje de las ciencias mediante la participación del alumnado en las prácticas científicas es un marco que está ganando impulso en la investigación educativa (NRC, 2012). De todas maneras, estas prácticas no son introducidas en la mayoría de las aulas, en las que predomina un enfoque centrado en los productos y no tanto en los procesos de la ciencia (Duschl y Grandy, 2008). Como señalan Lehrer y Schauble (2012), a pesar de que una parte central del trabajo científico consiste en construir, revisar, aplicar y proponer modelos para explicar fenómenos naturales, los modelos raramente se utilizan en el aula de ciencias. En la mayoría de los casos, se emplean como ilustraciones, más que como herramientas de construcción de conocimiento. En la enseñanza de la biología, la modelización puede ser una posibilidad efectiva (Duso, Clement, Barbosa Pereira y Alves Filho, 2013), y en el caso de la genética, ésta podría ayudar a mejorar la comprensión de mecanismos que ocurren a nivel molecular que se manifiestan a nivel macro.
Las prácticas científicas se corresponden en líneas generales con estos tres cuerpos de construcción de conocimiento investigados en didáctica de ciencias: a) la indagación, que implica el diseño y la puesta en práctica de experimentos y el análisis de datos obtenidos; b) la modelización, que conlleva explicar fenómenos naturales por medio de modelos; c) la argumentación, que implica evaluar el conocimiento en base a las pruebas. Existe una relación entre estos tres cuerpos que forman parte de las prácticas científicas y los procesos de desarrollo de competencias científicas de PISA por el alumnado (Jiménez Aleixandre, 2012)a.
Siguiendo a autoras como Mendoça y Justi (2014), consideramos que las prácticas de modelización y argumentación están íntimamente conectadas. En los últimos años, la investigación en modelización pone el énfasis en la importancia de explorar las relaciones entre estas dos prácticas en contextos de enseñanza que sean relevantes (Mendoça y Justi, 2014; Passmore y Svodoba, 2011), y en la influencia que tienen estas destrezas en el desarrollo de pensamiento crítico. La secuencia que proponemos pretende involucrar al alumnado en la articulación de las prácticas de modelización y argumentación en contextos reales relacionados con las enfermedades. Este artículo aborda una tarea que requiere modelizar la expresión de los genes para explicar una enfermedad genética. En la revisión de la literatura no hemos localizado estudios que analicen la modelización en este contexto de aprendizaje, siendo este estudio de gran interés para este campo de investigación y para la enseñanza de genética.
EL MODELO DE LA EXPRESIÓN DE LOS GENES EN LA ENSEÑANZA DE GENÉTICA
La genética es uno de los campos de mayor dificultad para el alumnado (e.g., Duncan & Reiser, 2007; Lewis & Wood-Robinson, 2000). La literatura agrupa estas dificultades en cinco dominios: 1) el vocabulario y la terminología específica; 2) el contenido matemático de las tareas de genética mendeliana; 3) los procesos citológicos; 4) la naturaleza abstracta de la genética y la manera de abordarse en el currículum, y 5) su complejidad, que implica procesos a nivel macro y micro.
A pesar de presentarse por separado, estos dominios están relacionados, y en el aprendizaje de éstos influyen no sólo los modelos de instrucción escolar, sino también otras fuentes de aprendizaje fuera del ámbito escolar. La alfabetización en genética tiene dos componentes que son interdependientes, uno relacionado con los contenidos científicos que se enseñan tradicionalmente en las aulas; y otro con cuestiones de educación para la ciudadanía, como la toma de decisiones para realizar un test genético (Kampourakis, 2014).
El desafío en la educación es abordar la genética en conexión con contextos reales que permitan la transferencia de conocimientos y el desarrollo de pensamiento crítico por el alumnado. Este estudio pretende proporcionar un ambiente de aprendizaje que favorezca la alfabetización en genética, mediante la modelización de la expresión de los genes. Se propone la modelización como medio para ayudar a visualizar y comprender procesos que no son visibles (Venville y Dawson, 2010), en este caso los mecanismos y entidades moleculares involucrados en la expresión de los genes y en la manifestación de enfermedades genéticas de diferente complejidad. La secuencia pretende promover la tranferencia del modelo de expresión de los genes para explicar enfermedades de diferente complejidad e incidencia social.
Los estudios que abordan el modelo de expresión de los genes ponen de manifiesto las dificultades del alumnado para entender las relaciones entre fenotipo y genotipo (Knippels, Waarloo e Boersma; 2005, Tsui e Treagust, 2007; Venville e Donovan, 2008), y los mecanismos y niveles de organización especificados por la información genética (Duncan, Rogat y Yarden, 2009). En genética, numerosos conceptos se sitúan en los niveles micro y submicro, como ADN, genes y cromosomas. Los estudiantes posiblemente conocen sus definiciones y son capaces de resolver problemas de genética, pero no tienen una comprensión de los conceptos involucrados en la resolución de los mismos (Bahar, Johnstone, y Sutcliffe, 1999).
Uno de los obstáculos para la comprensión del modelo de expresión de los genes por el alumnado son las posiciones deterministas, que atribuyen exclusivamente a los genes la presencia o ausencia de determinadas características (Puig y Jiménez A leixandre, 2011). Existe consenso científico que indica que estas características son el resultado de las interacciones de factores genéticos y ambientales (Lewontin, 2000), sin embargo la enseñanza tradicional de la genética en distintos niveles no ayuda a entender este modelo.
Estudios genómicos que tienen como objetivo identificar todos los factores genéticos relacionados con la salud y la enfermedad, ponen de relieve que la influencia de los factores genéticos individuales sobre la enfermedad es pequeña (Altshuler, Daly y Lander, 2008). Por lo tanto, encontrar asociaciones entre secuencias de ADN y el riesgo de contraer enfermedades no proporciona información clínica útil (Altshuler et al., 2008). Esto evidencia la necesidad de utilizar recursos que contemplen esta realidad.
METODOLOGÍA, PARTICIPANTES Y SECUENCIA
La investigación se enmarca dentro de los estudios cualitativos (Denzin y Lincoln, 2000), por lo que el objetivo es acercar puntos de reflexión y acción para la mejora de la práctica educativa. Dentro de estos enfoques, se escoge realizar un estudio de caso detallado basado en la observación de un grupo aula de un centro de secundaria de Galicia.
Los participantes son veinte estudiantes de 4º de ESO (de entre 15 y 16 años), curso en el que la Biología y Geología, materia en la que se integra la secuencia, es optativa para el alumnado. El alumnado trabajó a lo largo de la secuencia en grupos de cuatro, configurados bajo criterio de los docentes, tratando de alcanzar mayor homogeneidad entre ellos.
Además, participan en el estudio los dos profesores de Biología y Geología de los estudiantes. Para el diseño de la secuencia se establecieron diversas reuniones con los dos docentes para discutir aspectos sobre el enfoque de enseñanza de modelización y el diseño de las tareas. Ambos utilizan modelos para la enseñanza de la Biología y la Geología en sus aulas, que proceden de textos de ciencias, o son modelos materiales ampliamente usados. Hay que destacar que uno de los docentes tiene experiencia en el diseño de tareas de modelización para el aula y ha colaborado previamente en una investigación de modelización en el contexto de geología.
Unidad didáctica: Fue diseñada para 4º ESO por ser el nivel educativo donde se trabajan los contenidos de genética de la secuencia. El diseño utiliza enfoque constructivista basado en el aprendizaje de ciencias mediante la participación en las prácticas científicas (OECD, 2013).
La secuencia comprende cuatro actividades desarrolladas en siete sesiones, además de un pre-test para identificar ideas previas del alumnado sobre modelos y modelización, y desarrollo de enfermedades. Las actividades se realizaron de manera integrada con los contenidos trabajados previamente por el profesorado. La tabla 1 resume las actividades de la secuencia.


En el presente artículo nos centramos en el análisis de la primera actividad, Explicar la anemia falciforme con el modelo de expresión de los genes, que requiere construir y aplicar el modelo de expresión de los genes para explicar la anemia falciforme seleccionando entre una serie de elementos proporcionados. Se eligió esta enfermedad por tres razones: a) ser fácilmente reconocible a través del fenotipo, lo que permitía partir de éste para construir el modelo; b) ser una enfermedad monogénica, y por lo tanto, más sencilla para elaborar el modelo; c) ser de recién incorporación a las pruebas de cribado neonatal que analizan los genotipos de recién nacidos en nuestro sistema sanitario público (ver anexo 1).
Con el objetivo de facilitar la modelización de la expresión de los genes por parte del alumnado, proporcionamos un kit expresión de los genes que incluye estos materiales (imagen 1): una cartulina grande que representa el medio extracelular; dos círculos de cartulina de diferente color y tamaño que corresponden al citoplasma y al núcleo; varias copias de la secuencia de ADN, varias copias de la secuencia de ARN, varias tiras de papel en blanco para traducir la secuencia de aminoácidos; un código genético; un puzzle que representa un fragmento de la proteína; un cromosoma; las dos subunidades separadas de un ribosoma, tijeras, pegamento y rotuladores. El alumnado debe identificar y seleccionar los materiales del kit para construir su modelo. Hay que destacar que ningún elemento aparecía identificado, de tal modo que el alumnado debe identificarlos para elaborar sus modelos.

La actividad se realizó durante dos sesiones de 50 minutos en pequeños grupos. En el anexo 1 se reproducen las preguntas de la tarea. Los docentes guiaron en todo momento la actividad, siendo su papel el de guías en la construcción del modelo que proporcionan el andamiaje necesario para que el alumnado pudiera progresar en la modelización.
Etapas de la actividad "Explicar la anemia falciforme con el modelo de expresión de los genes"
El enfoque de la tarea atiende a las cuatro etapas de modelización propuestas por Justi (2006) que son: 1) Expresar el modelo mental (EX); 2) Construir el modelo (C); 3) Comunicar el modelo (CO); 4) Evaluar el modelo (E).
A pesar de que estas etapas se numeran de forma continua, podrían alternarse y repetirse a lo largo del proceso de modelización.
Recogida y análisis de datos: Todas las actividades de la unidad didáctica fueron grabadas en vídeo y en audio para su posterior análisis. En el caso de la tarea que analizamos en este artículo, fue necesario situar una grabadora de audio y una cámara de video por grupo para lograr registrar las interacciones entre los estudiantes y el proceso de modelización dentro de los cinco grupos. Además, la investigadora, que estuvo en todas las sesiones como observadora pasiva, realizó anotaciones de campo acerca de la marcha de la actividad y de los roles que aparecían dentro de los grupos, además de otros aspectos relevantes para el análisis.
Los datos recogidos incluyen los informes escritos de la actividad (presentada en el anexo 1) elaborados por los cinco grupos y los modelos materiales construidos con el kit expresión de los genes.
Para responder a la primera pregunta de investigación, ¿Cómo son los modelos materiales que elaboran los estudiantes de secundaria para explicar la expresión de los genes?, fue necesario el análisis de los modelos materiales elaborados con el kit. El análisis se centra en los elementos del kit seleccionados, su identificación y su integración dentro del modelo. La rúbrica elaborada (tabla 2) se basa en otras herramientas previas que analizan modelos expresados en otros contextos de aprendizaje de temas de salud (Aznar y Puig, en prensa).
La segunda pregunta, ¿En qué medida explican la expresión de los genes en base a los modelos elaborados y los relacionan con la anemia falciforme?, pretende comprobar el nivel de coherencia entre los modelos elaborados por los grupos y las explicaciones que dan sobre éstos. De acuerdo con Justi (2006), consideramos que estas dos operaciones o fases de la modelización pueden solaparse, puesto que no son independientes. En nuestro caso, el diseño de la tarea permite analizar ambas operaciones por separado.
Los cinco grupos tenían primero que construir el modelo, explicar después la expresión de los genes en base a éste, y finalmente presentarlo a toda el aula.
Los datos analizados para responder a esta segunda pregunta son los modelos materiales y las explicaciones escritas de los mismos. Además, analizamos la presentación oral de los distintos grupos sobre sus modelos al resto del aula, para lo que fue necesaria la transcripción de toda la sesión.
RESULTADOS
¿Cómo son los modelos materiales que elaboran los estudiantes de secundaria para explicar la expresión de los genes?
En este apartado se discuten los resultados de los modelos materiales elaborados por los cinco grupos. El análisis presta atención a los elementos que incluyen en los modelos y a la forma en que los integran. La tabla 2 resume estos resultados. Cabe señalar que el proceso de modelización fue guiado por los docentes, quienes orientaron al alumnado en la identificación de los elementos y en la secuenciación de los procesos involucrados en la expresión de los genes. Los conocimientos necesarios para la elaboración del modelo fueron previamente trabajados en el aula.


La mayoría de los grupos utiliza todos los materiales suministrados para construir el modelo, excepto el cromosoma, que un grupo decide no incluirlo en su modelo, justificándolo así: "que la célula no está en división". Otros dos grupos incluyen cromosoma, aunque no están de acuerdo, como reflejan en el informe escrito: "no encuentran lógico que se formen los cromosomas en presencia del núcleo, pues cuando estos se forman la envuelta nuclear desaparece".
El elemento que presenta más discrepancias a la hora de nombrarlo es el ribosoma. Dos grupos lo incorporan acoplado al retículo endoplasmático (RE) rugoso e identifican parte del propio ribosoma como RE. Incluso un grupo atribuye al RE la capacidad de dirigir el proceso de traducción, en lugar de indicar que ocurre en el ribosoma.
En los modelos de tres grupos la proteína aparece nombrada como "parte de la proteína", lo que muestra que estos estudiantes identifican que las proteína están formadas por cientos de aminoácidos, y para modelizar de manera sencilla la expresión de los genes se selecciona un fragmento específico.
Respecto a la forma en la que los grupos sitúan los elementos del modelo, la mayoría lo hace de acuerdo al modelo escolar de referencia, siguiendo el orden de los procesos que intervienen en la expresión de los genes. Sin embargo, no todos son capaces de nombrar los procesos, como el grupo 2. Tres de los cinco grupos indican la transcripción, dos la traducción y dos mencionan la "lectura", lo que podríamos equiparar a la traducción. Ubicar correctamente ambos procesos, la transcripción y la traducción, no resulta fácil para el alumnado. Dos (1 y 3) ubican de manera adecuada la transcripción y traducción en el núcleo y en el citoplasma respectivamente, pero los otros dos no lo hacen. El grupo 5 no indica la transcripción pero la "lectura" la sitúa en el citoplasma. El grupo 4 localiza ambos procesos en el citoplasma.
La figura 1 trata de representar los elementos y los procesos incluidos en los modelos de los cinco grupos y como los relacionan. Se muestra el número de grupos capaces de establecer conexiones entre las distintas fases de la expresión de los genes.

Dos grupos no son capaces de relacionar los elementos del modelo. En un caso (grupo 5) se limitan a identificarlos y a situarlos en el citoplasma, y en otro (grupo 2), identifican sólo algunos y los sitúan, tanto dentro como fuera de la célula.
Tres grupos relacionan los elementos y procesos que intervienen en la expresión de los genes correctamente, aunque uno de ellos (grupo 1) relaciona tanto el ARN como la cadena de aminoácidos con la proteína. No indican la relación específica entre la cadena de aminoácidos y el ARN, pero si aclaran por escrito en su modelo que la traducción es el "paso del lenguaje del ARN al lenguaje de los aminoácidos".
Las imágenes 2 y 3 muestran los modelos representados por el grupo 1 y 2, que consideramos representativos ya que corresponden a los de menor y mayor grado de complejidad.


E modelo del grupo 2 (imagen 2 ) incluye algunos elementos, aunque no los localizan ni relacionan adecuadamente. Muestran un modelo estático, donde no se representan las transcripción y la traducción, pero sí la síntesis de proteínas como un elemento más.
Este grupo se limita a nombrar cada uno de los elementos, como si el objetivo de la modelización fuera el de reconocer qué elementos de los entregados en la tarea participan en la expresión de los genes. No son capaces de establecer conexiones entre las moléculas de ADN, ARN, cadenas de aminoácidos y proteína; señalando exclusivamente el orden de lectura del ARN y ejecutando la tarea de codificar la cadena de aminoácidos.
El modelo del grupo 1 (imagen 3) es el contrario del anterior, dinámico en el sentido de que se representan y relacionan los procesos que participan en la expresión de los genes. Además de incluir los elementos, procuran explicar los distintos pasos y elementos involucrados. Distinguen las partes del cromosoma y justifican la inclusión de dos fibras de ADN en el modelo. Señalan como tiene lugar la lectura y ejecutan la tarea de codificar la secuencia de aminoácidos.
¿En qué medida explican la expresión de los genes en base a los modelos elaborados y los relacionan con la anemia falciforme?
Para responder a esta pregunta es necesario analizar los modelos materiales y las explicaciones que dan sobre éstos (tanto escritas como orales) los cinco grupos. Pretendemos comprobar si la elaboración de los modelos con el kit expresión de los genes ayudó a los estudiantes a construir una explicación sobre la expresión de los genes y en qué medida lo hizo.
Podemos señalar que todos los grupos emplean sus modelos para explicar la expresión de los genes. Los cinco grupos logran mejorar y ampliar sus modelos al explicarlos oralmente o por escrito. La tabla 2 resume los modelos materiales, las explicaciones escritas y la presentación oral de los modelos de los cinco grupos.
Como muestra la tabla 3, cuatro de los cinco grupos amplían la información relativa a los procesos, siendo capaces de relacionar algunos elementos que intervienen en la expresión de los genes. En el caso del grupo 1, son capaces de explicar oralmente la fase de traducción de manera detallada. El resto de los grupos logran dinamizar sus modelos cuando los explican.
Hay que destacar que un grupo, el 2, focaliza más la atención en describir cómo identificaron los elementos del modelo y los pasos que siguieron para elaborar éstos, que en explicar la expresión de los genes.
Grupo 2: "Primero deducimos que el circulo amarillo era la célula y el azul el núcleo, y el circulo marrón el ribosoma (...). Nos dimos cuenta de que los recortes con dos secuencias de letras correspondían con las cadenas dobles de ADN (...)."

Respecto a la capacidad para conectar sus modelos con la anemia falciforme, encontramos que dos grupos (el 1 y el 5) hacen referencia de manera más o menos explícita a esta enfermedad en sus explicaciones escritas. En el caso del grupo 1, los estudiantes construyen sus modelos a partir del fenotipo de anemia falciforme presentado en la tarea (ver anexo 1), de tal modo que al identificar los elementos del kit expresión de los genes para elaborar el modelo, atienden a características de los glóbulos rojos, células que presentan forma anómala en personas enfermas. La explicación de este grupo comienza así: "Los glóbulos rojos sólo presentan núcleo en la fase de maduración (...)"
En el caso del grupo 5, inician la explicación de este modo: "Realizamos un modelo que muestra a la célula de la anemia falciforme creando proteínas (...)".
No existen más referencias a la anemia hasta que los estudiantes comparan sus modelos con el resto de los grupos. Los mismos grupos de antes, el 1 y el 5, son capaces de relacionar la mutación en la cadena de aminoácidos con personas enfermas o sanas, como muestran sus respuestas escritas:
Grupo 1: "Creemos que el nuestro es un organismo anémico porque se repite el ácido glutámico en la cadena de aminoácidos mientras que en los otros grupos esto no ocurre (presentan valina y nosotros no)"
Grupo 5: "Realizamos el modelo que muestra a la célula de la anemia falciforme. Nuestra proteína posee en el medio ácido glutámico y la proteína verde tiene en el centro valina, de hecho que uno pertenece a un organismo enfermo"
El resto de grupos identifican los cambios de aminoácido, pero no lo atribuyen a la anemia falciforme.
CONCLUSIONES E IMPLICACIONES PARA EL AULA
La tarea que se analiza en este artículo pretende ayudar al alumnado de secundaria a visualizar y a fijar los elementos y mecanismos involucrados en la expresión de los genes. Se trata de una tarea inicial integrada en una secuencia para promover la transferencia de este modelo a distintos contextos relacionados con diversas enfermedades genéticas.
El análisis muestra que todos los grupos movilizaron ideas y nociones de genética para representar y explicar el modelo de expresión de los genes, aunque algunos modelos materiales, como los de los grupos 2 y 5, no explicitan los procesos ni las relaciones entre los elementos. El análisis de las explicaciones escritas y orales de los modelos muestra que todos los grupos logran mejorar sus modelos de manera significativa, incorporando o ampliando información relativa a los procesos. En el caso de los dos grupos anteriores, logran conectar los elementos que previamente se limitaban a nombrar en sus modelos materiales.
Estos resultados ponen de relieve el potencial de utilizar un enfoque de modelización en el aula que incorpore las fases propuestas por Justi (2006). Este enfoque involucra al alumnado en distintas operaciones relacionadas con la construcción de modelos, que incluyen no sólo la representación, sino también la justificación y la comunicación de éstos al resto del aula.
En este trabajo, pudimos comprobar que el proceso de construcción de explicaciones y la fase de comunicación de modelos por parte de los grupos favorece su revisión y la mejora de los mismos. Dicho de otro modo, la modelización de la expresión de los genes con el kit parece ayudar al alumnado a elaborar una explicación sobre los mecanismos que intervienen en la expresión de los genes.
Por otro lado, nuestros resultados coinciden con los previamente señalados por autores como Duncan, Rogat y Yarden (2009), que ponen de relieve las dificultades del alumnado para entender mecanismos genéticos. La mayor parte de los grupos en este estudio tienen dificultades para ubicar de manera adecuada los procesos de transcripción y/o traducción dentro de la célula. Proponemos que nuestra actividad podría orientarse de tal modo que ayudemos al alumnado a superar estas dificultades, realizando un ejercicio de comparación entre sus modelos y una posterior puesta en común guiada por el docente.
Otro resultado a destacar es que la mayoría no hace referencia a la anemia falciforme hasta poner en común sus modelos. A pesar de que el docente formuló la actividad a partir de la presentación de imágenes de muestras sanguíneas de individuos con y sin anemia falciforme, la mayoría no relacionó el modelo con esta enfermedad hasta el final. Este resultado podría explicarse porque era la primera actividad de la secuencia y el alumnado no había participado previamente en otras actividades de modelización. Por otro lado, el propósito de esta tarea era introducir al alumnado en la práctica de la modelización, para desarrollar después otras tareas que abordan enfermedades genéticas de mayor complejidad. Cabe seguir investigando esta práctica a lo largo de la secuencia, para poder conocer en mayor profundidad la utilidad de este enfoque en el aprendizaje de enfermedades y en la comprensión del modelo de expresión de los genes por parte del alumnado de secundaria.
AGRADECIMIENTOS
A todos los participantes en el estudio. Al proyecto EDU2012-38022-C02-01, financiado por el Ministerio de Economía y Competitividad de España, del que forma parte este trabajo.
BIBLIOGRAFÍA
ALTSHULER, D.; DALY, M. J.; Y LANDER, E. S. Genetic mapping in human disease. Science, v. 322, p.881-888. 2008.
AZNAR, V.; PUIG, B. ¿Qué conocimientos movilizan un grupo de futuros docents para elaborar el modelo de infección por tuberculosis? Revista Eureka sobre Enseñanza y Divulgación de las Ciencias, en prensa, 2016.
PUIG, B.; JIMÉNEZ-ALEIXANDRE. Different music to the same score: teaching about genes, environment and human performances. En: T. D. Sadler (Ed), Socio-scientific issues in the classroom: teaching, learning and research (201-238). Dordrecht: Springer, 2011.
BAHAR, M.; JOHNSTONE, A. H.; SUTCLIFFE, R. G. Investigation of student's cognitive structures in elementary genetics through word association tests. Journal of Biological Education, v. 33(3), p.134-141. 1999.
DENZIN, N. K.; Y LINCOLN, Y. S. The discipline and practice of qualitative research. En: N. K. Denzin; Y. S. Lincoln (eds.). Handbook of Qualitative Research (1-28). Second Edition. California: Sage Publications, 2000.
DUNCAN, R. G.; REISER, B. J. Reasoning across ontologically distinct levels: Students' understandings of molecular genetics. Journal of Research in Science Teaching, v. 44(7), p. 938-959. 2007.
DUNCAN, R. G.; ROGAT, A. D.; YARDEN, A. A learning progression for deepening students' understanding of modern genetics across the 5th-10th grades. Journal of Research in Science Teaching, v. 46(6), p. 655-674. 2009
DUSCHL, R. A.; GRANDY, R. E. Reconsidering the character and role of inquiry in school science: framing the debates. In: R. A. Duschl; R.E. Grandy (Eds.), Teaching scientific inquiry. Recommendations for research and implementation. Rotterdam: Sense Publisher, 2008, p. 1-37.
DUSO, L.; CLEMENT, L.; BARBOSA PEREIRA, P.; DE PINHO ALVES FILHO; J. Modelização: uma possibilidade didática no ensino de biologia. Ensaio Pesquisa em Educação em Ciências, vol. 15, núm. 2, mayo-agosto, 2013, pp. 29-44.
JIMÉNEZ ALEIXANDRE, M. P. Determinism and Underdetermination in Genetics: Implications for Students' Engagement in Argumentation and Epistemic Practices. Science & Education, v. 2, p. 465-484. 2012.
JIMÉNEZ ALEIXANDRE, M. P. Las prácticas científicas en la investigación y en el aula de ciencias. Conferencia plenaria. XXV Encuentro de Didáctica de las Ciencias Experimentales, 5-7 de septiembre de 2012.
JUSTI, R. La enseñanza de ciencias basada en la elaboración de modelos. Enseñanza de las ciencias, v. 24(2), p. 173-184. 2006.
KAMPOURAKIS, K.; REYDON, T. A. C.; PATRINOS, G. P.; STRASSER, B. J. Genetics and Society-Education Scientifically Literature Citizens: Introduction to the Thematic Issue. Science & Education, v. 23, p. 251-258. 2014.
KNIPPELS M. C. P. J.; WAARLOO, A. J.; BOERSMA, K. TH. Design criteria for learning and teaching genetics. Journal of Biological Education, v. 39(3), p. 109-112. 2005.
LEHRER Y SCHAUBLE. Seeding evolutionary thinking by engaging children in modeling its foundations. Science Education, v. 96(4), p. 701-724. 2012.
LEWIS, J.; WOOD ROBINSON C. Genes, chromosomes, cell division and inheritance- do students see any relationship? International Journal of Science Education, v. 22(2), p. 177-195. 2000.
LEWONTIN, R. C. What do population geneticists know and how do they know it? En: R. Creath; J. Maienschein (Eds.), Biology and epistemology. Cambridge: Cambridge University Press, 2000. p. 191-214.
MENDONÇA, P.C.C.; JUSTI, R. An instrument for analyzing arguments produced in modeling-based Chemistry lessons. Journal of Research in Science Teaching, v. 51(2), p. 192- 218. 2014.
NATIONAL RESEARCH COUNCIL. A Framework for K-12 Science Education: Practices, crosscutting concepts, and core ideas. Washington, DC: National Academies Press, 2012.
ORGANISATION FOR ECONOMIC COOPERATION AND DEVELOPMENT (OECD). PISA 2015 Draft Science Framework. OECD, 2013.
PASSMORE; C. M.; Y SVODOBA, J. Exploring opportunities for argumentation in Modelling Classrooms. International Journal of Science Education, v. 34(810), p. 1535-1554. 2011.
TSUI, C. Y.; TREAGUST, D. F. Understanding Genetics: Analysis of Secondary students´conceptual status. Journal of Research in Science Teaching, v. 44(2), p. 205-235. 2007.
VENVILLE, G.; e DAWSON, V. The impact of an argumentation intervention on Grade 10 students' conceptual understanding of genetics. Journal of Research in Science Teaching, v. 47(8), p. 952-977. 2010.
VENVILLE G.; DONOVAN, J. How pupils use a model for abstract concepts in genetics. Journal of Biological Education, v. 43(1), p. 6-14. 2008.
ANEXO 1
ACTIVIDAD: "Explicar la anemia falciforme con el modelo de expression de le los genes"
La tarea muesta dos imágenes a microscopio de dos muestras, una de ellas de un individuo con anemia falciforme y otro individuo no afectado por la enfermedad. Además, se contextualiza la actividad con la noticia que aparece a continuación.

Se pide al alumnado que explique las semejanzas y diferencias entre las imágenes y después de una puesta en común realiza las siguientes actividades:
1. Como se llega a formar el fenotipo desde la información contenida en el ADN?
2. Elaborad el modelo de expresión de los genes para explicar la anemia falciforme.
Preguntas para cada grupo
2.1. Explicad vuestro modelo
2.2. Que criterios habeis seguido para construilo?
2.3. El modelo fue consensuado en el grupo? Explicarlo.
2.4. Presentad al resto de compañeros el póster con el modelo de expresión.
Notas de autor
Contato: Noa Ageitos Prego/Blanca Puig - Departamento de Didáctica das Ciencias Experimentais, Facultade de Ciencias da Educación. Campus Norte, Universidade de Santiago de Compostela (USC), Avd. Xoán XXIII, s/n, 15782 Santiago de Compostela. Galicia. España